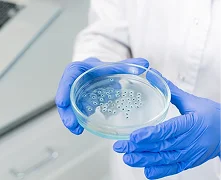

آزمایشگاه پاتوبیولوژی و ژنتیک پارسه
آزمایشگاه پاتوبیولوژی و ژنتیک پارسه از سال ۱۳۸۳ فعالیت خود را با هدف ارائه خدمات تخصصی و دقیق در حوزههای مختلف علوم آزمایشگاهی آغاز کرده است. این مرکز اکنون به عنوان یکی از آزمایشگاههای مرجع کشور، در فضایی بیش از ۱۲۰۰ متر مربع در غرب تهران، با بهرهگیری از تجهیزات پیشرفته، فناوریهای نوین و تیمی از متخصصان مجرب به مراجعان و مراکز درمانی خدماترسانی میکند.
حوزههای تخصصی فعالیت این مجموعه شامل پاتولوژی، ژنتیک، هماتولوژی، بیوشیمی، ایمونولوژی، میکروبشناسی و هورمونشناسی است که همگی با رعایت بالاترین استانداردهای کیفی و کنترل دقیق نتایج انجام میشوند.
در آزمایشگاه پارسه، دقت، سرعت و پاسخگویی مسئولانه در کنار رویکردی دانشمحور، بنیان اصلی اعتماد بیماران و پزشکان به شمار میرود.
ریاست، مؤسس و مسئول فنی آزمایشگاه پارسه
مسئول فنی بخش ژنتیک
مدیر و مسئول فنی آزمایشگاه پارسه
بخش های آزمایشگاه
معرفی بخش های آزمایشگاه پاتوبیولوژی و ژنتیک پارسه